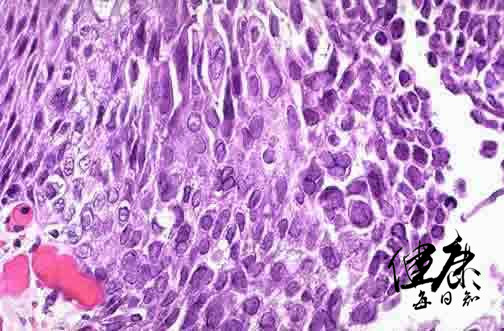
嘴巴上火起泡是病毒还是细菌,病毒性上火嘴上长泡多久能好

这段时间持续的高温,令人们心烦意乱,情绪也容易暴躁,有些人的嘴唇上就会出一些水泡,很多人觉得只是身体上火,没什么大不了的,多喝一点水就会自行消失!也有一些人经常性的加班熬夜,身体疲乏的时候,嘴唇上也出现一串一串的水泡,那种钻心的疼痛令人很苦恼,吃过退火的药物后,水泡也能自行的消失,但是一熬夜水泡就再度出现,这是因为什么呢?

这在中医上的确会归结于上火,但是在西医临床上则认为是一种病毒。这种在嘴唇上引起水泡的病毒叫做单纯疱疹病毒HSV-1,是一种疱疹病毒!
单纯疱疹病毒HSV-1
单纯疱疹病毒他会引起多种疾病,如龈口炎、角膜结膜炎、脑炎以及生殖系统感染和新生儿的感染。是一种典型的可传染性病毒。这种病毒在感染患者后,就会感染神经细胞,一旦感染后就会出现嘴唇长水泡的症状,并且在人群中通过空气,飞沫和身体接触来传播。

单纯疱疹病毒感染患者后会释放出大量病毒,并在患者接触他人时感染到到另一个宿主的体表。这种病毒会通过表明的糖蛋白媳妇在我们健康的细胞之上,然后钻破健康的细胞膜进入内部,将自己的DNA融入细胞核,操纵细胞制造大量的病毒,最终通过宿主细胞进一步感染周围健康的细胞。

这种病毒通常最爱潜伏者我们头部的三叉神经的神经节,免疫细胞在这里权限不足,只能有限的控制病毒复制,但不能消灭它们。单纯疱疹病毒就会终生的潜伏下来,当你身体匮乏,免疫功能减退,病毒就会顺着轴突末梢直奔面部,再制造出几个水泡,传染给他人——单纯疱疹病毒引发的面部水泡是一种世界性的疾病,在我国接近1/3的成年人每年发作两次以上。在你的身上有没有发生过呢?

如果你或者家人朋友的嘴唇出现了这些水泡,如果服用去*药火**,只能有限的控制一两天,要想稳定的控制不再复发,你可以试一试这一些方法:

多吃新鲜果蔬,补充各种维生素,过喝水,以增强机体免疫力,保持体内营养平衡,防止水泡的发生。
富含精氨酸的食物一定少吃,如巧克力、可乐、豌豆、谷类麦片、花生、明胶、腰果、啤酒等。